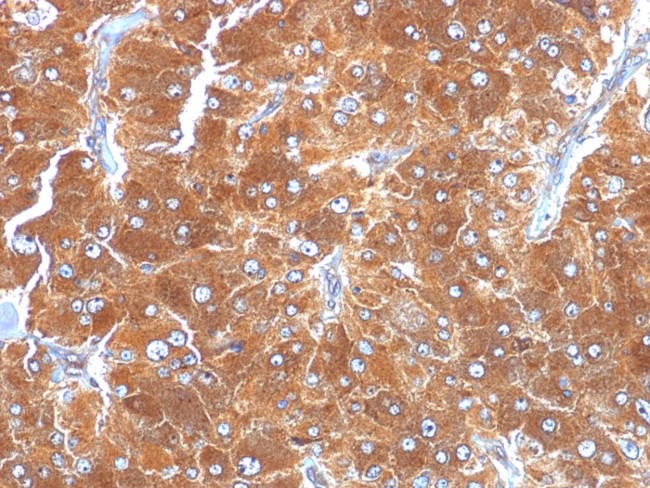
Adipophilin/Perilipin-2 (Marker of Lipid Accumulation) Antibody in Immunohistochemistry (Paraffin) (IHC (P))

Search
NeoBiotechnologies
Adipophilin/Perilipin-2 (Marker of Lipid Accumulation) Monoclonal Antibody (ADFP/1494)
{{$productOrderCtrl.translations['antibody.pdp.commerceCard.promotion.promotions']}}
{{$productOrderCtrl.translations['antibody.pdp.commerceCard.promotion.viewpromo']}}
{{$productOrderCtrl.translations['antibody.pdp.commerceCard.promotion.promocode']}}: {{promo.promoCode}} {{promo.promoTitle}} {{promo.promoDescription}}. {{$productOrderCtrl.translations['antibody.pdp.commerceCard.promotion.learnmore']}}
产品信息
123-MSM4-P0
种属反应
宿主/亚型
分类
类型
克隆号
抗原
偶联物
形式
浓度
规格
纯化类型
保存液
内含物
保存条件
运输条件
靶标信息
Milk lipid globules from humans, cows and rats contain a protein identified as adipocyte differentiation-related protein (ADFP). It is associated with the globule surface membrane material. This protein, previously believed to be specific to adipocytes, is a major constituent of the globule surface and is present in a detergent-insoluble complex that contains butyrophilin and xanthine oxidase. ADFP (Adipophilin) is found in a wide range of cultured cell lines, including fibroblasts, endothelial and epithelial cells. In tissues, however, expression of adipophilin is restricted to specific cell types, such as lactating mammary epithelial cells, adrenal cortex cells, Sertoli and Leydig cells of the male reproductive system, and steatosis or fatty change hepatocytes in alcoholic liver cirrhosis. ADFP may be a possible new marker for the identification of specialized differentiated cells containing lipid droplets and for diseases associated with fat-accumulating cells.
仅用于科研。不用于诊断过程。未经明确授权不得转售。
篇参考文献 (0)
生物信息学
蛋白别名: ADFP; Adipophilin; Adipose differentiation-related protein; ADRP; ADRP antibody; MGC10598; Perilipin-2; unnamed protein product
基因别名: ADFP; ADRP; PLIN2
UniProt ID: (Human) Q99541
Entrez Gene ID: (Human) 123